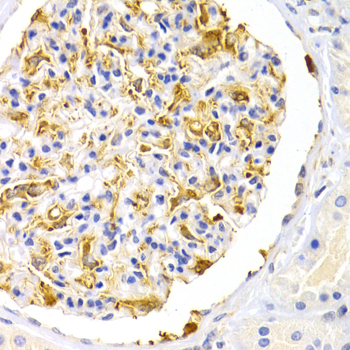
A2999: image 4

For quotations, please use our online quotation form, and you may also contact us by
service@kendallscientific.com
+1-888.733.6849 (Toll-free)
+1-617.299.7367 (Int’l))
+1-888.733.6849
Our customer service representatives are available 24 hours, Monday through Friday to assist you.| Reactivity | Human Mouse Rat |
| Tested applications | WB IHC |
| Recommended Dilution | WB 1:500 - 1:1000 IHC 1:50 - 1:100 |
| Calculated MW | 96kDa |
| Observed MW | Refer to Figures |
| Immunogen | A synthetic peptide of human LEPR |
| Storage Buffer | Store at -20℃. Avoid freeze / thaw cycles. Buffer: PBS with 0.02% sodium azide, 50% glycerol, pH7.3. |
| Synonym | OBR; OB-R; CD295; LEP-R |

Western blot analysis of extracts of various cell lines, using LEPR antibody.

Immunohistochemistry of paraffin-embedded Human colon cancer tissue using LEPR antibody.

Immunohistochemistry of paraffin-embedded rat lung using LEPR antibody at dilution of 1:200 (400x lens).
Immunohistochemistry of paraffin-embedded mouse kidney using LEPR antibody at dilution of 1:200 (400x lens).
The protein encoded by this gene belongs to the gp130 family of cytokine receptors that are known to stimulate gene transcription via activation of cytosolic STAT proteins. This protein is a receptor for leptin (an adipocyte-specific hormone that regulates body weight), and is involved in the regulation of fat metabolism, as well as in a novel hematopoietic pathway that is required for normal lymphopoiesis. Mutations in this gene have been associated with obesity and pituitary dysfunction. Alternatively spliced transcript variants encoding different isoforms have been described for this gene. It is noteworthy that this gene and LEPROT gene (GeneID:54741) share the same promoter and the first 2 exons, however, encode distinct proteins (PMID:9207021).
N/A